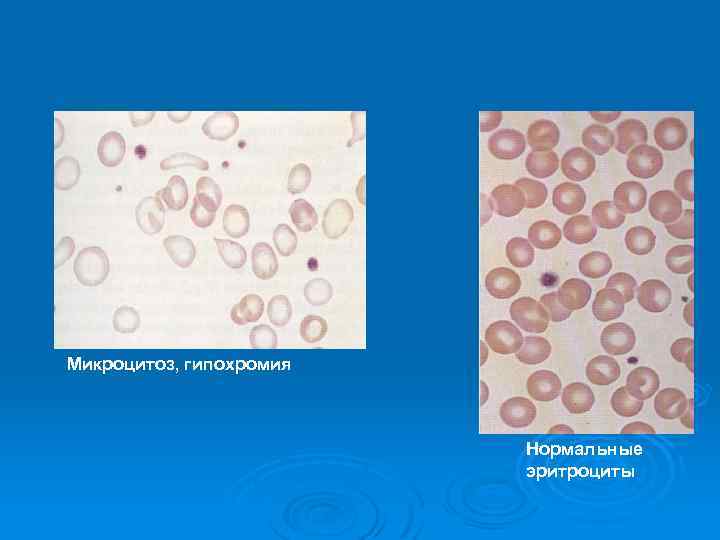
Микроцитоз, гипохромия Нормальные эритроциты
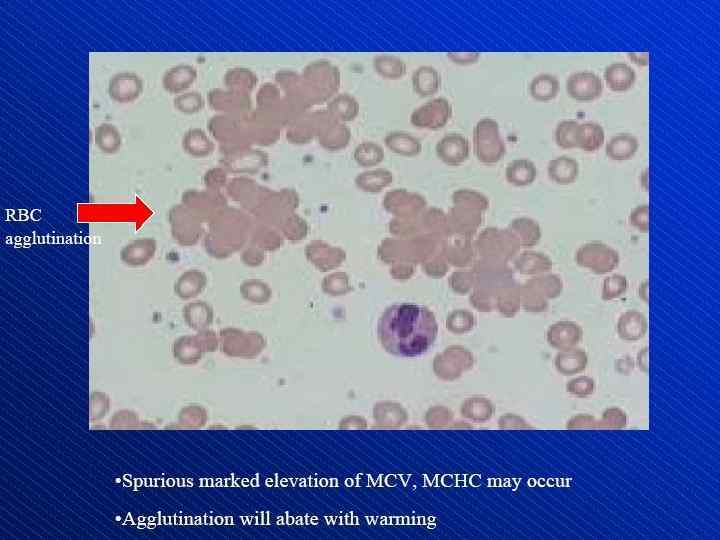

Анемии Барях.ppt
- Количество слайдов: 130
 Анемии. Клиника. Диагностика. Лечение.
Анемии. Клиника. Диагностика. Лечение.
 Анемия Снижение числа эритроцитов и уровня гемоглобина в организме из-за q кровопотери, q нарушения продукции клеток эритропоэза, q повышенного разрушения эритроцитов или q их сочетания.
Анемия Снижение числа эритроцитов и уровня гемоглобина в организме из-за q кровопотери, q нарушения продукции клеток эритропоэза, q повышенного разрушения эритроцитов или q их сочетания.
 Эритрон Стволовая клетка Клетка – предшественница миелопоэза Клетка - предшественница эритропоэза Проэритробласт Эритробласт Нормобласт Ретикулоциты Эритроциты
Эритрон Стволовая клетка Клетка – предшественница миелопоэза Клетка - предшественница эритропоэза Проэритробласт Эритробласт Нормобласт Ретикулоциты Эритроциты
 мегалобласт нормобласт Появляется в периферической крови при миелофиброзе, метастазах рака, миелодиспластическом синдроме, гемолизе сидеробласт
мегалобласт нормобласт Появляется в периферической крови при миелофиброзе, метастазах рака, миелодиспластическом синдроме, гемолизе сидеробласт
 Анемия Есть Нет Снижение Гемодилюция абсолютного числа эритроцитов
Анемия Есть Нет Снижение Гемодилюция абсолютного числа эритроцитов
 Гемодилюция Снижение концентрации гемоглобина и эритроцитов в единице объема крови на фоне увеличенного объема циркулирующей плазмы и нормального количества циркулирующих эритроцитов: - Неадекватная инфузионная терапия - Задержка жидкости в сосудистом русле (например, у беременных, во второй период острой кровопотери) Ø
Гемодилюция Снижение концентрации гемоглобина и эритроцитов в единице объема крови на фоне увеличенного объема циркулирующей плазмы и нормального количества циркулирующих эритроцитов: - Неадекватная инфузионная терапия - Задержка жидкости в сосудистом русле (например, у беременных, во второй период острой кровопотери) Ø
 Повышенная потеря Ø Острая постгеморрагическая анемия. Ранний период (1 -2 сутки)- генерализованный спазм сосудов, компенсаторное поступление в циркуляцию депонированной крови Второй период (2 -3 сутки)-поступление в кровоток большого количества тканевой жидкости. Развивается нормохромная нормоцитарная анемия. Третий период (5 -6 сутки)- повышенная пролиферация клеток эритрона. Появление ретикулоцитов в периферической крови. Полная нормализация лабораторных данных- через 2 -3 недели.
Повышенная потеря Ø Острая постгеморрагическая анемия. Ранний период (1 -2 сутки)- генерализованный спазм сосудов, компенсаторное поступление в циркуляцию депонированной крови Второй период (2 -3 сутки)-поступление в кровоток большого количества тканевой жидкости. Развивается нормохромная нормоцитарная анемия. Третий период (5 -6 сутки)- повышенная пролиферация клеток эритрона. Появление ретикулоцитов в периферической крови. Полная нормализация лабораторных данных- через 2 -3 недели.
 Недостаточное образование Ø Ø Ø Ø Ø Железодефицитная анемия Сидероахрестическая анемия Нарушение реутилизации железа Дефицит витамина В 12 и фолиевой кислоты Апластическая анемия Сидеробластная анемия (МДС) Метапластические анемии: при лейкозах, метастазах рака в костный мозг Гипопролиферативные анемии (заболевания почек, анемия хронических заболеваний) Дизэритропоэтическая анемия
Недостаточное образование Ø Ø Ø Ø Ø Железодефицитная анемия Сидероахрестическая анемия Нарушение реутилизации железа Дефицит витамина В 12 и фолиевой кислоты Апластическая анемия Сидеробластная анемия (МДС) Метапластические анемии: при лейкозах, метастазах рака в костный мозг Гипопролиферативные анемии (заболевания почек, анемия хронических заболеваний) Дизэритропоэтическая анемия
 Повышенное разрушениегемолиз Ø Наследственные: - Мембранопатии - Гемоглобинопатии - Ферментопатии Ø Приобретенные: - Аутоиммунные - Пароксизмальная ночная гемоглобинурия - Травматические - Отравления гемолитическими ядами и бактериальными токсинами
Повышенное разрушениегемолиз Ø Наследственные: - Мембранопатии - Гемоглобинопатии - Ферментопатии Ø Приобретенные: - Аутоиммунные - Пароксизмальная ночная гемоглобинурия - Травматические - Отравления гемолитическими ядами и бактериальными токсинами
 Диагностические критерии Лабораторный показатель Гемоглобин г/л Эритроциты х1012/л Нt % 5, 0 0, 8 4, 8 0, 6 47 5 42 5 Норма м ж 130 2 120 2 Диагностичес-кие критерии анемии м ж менее 130 менее 120 менее 4, 5 менее 4, 0 менее 42 менее 37
Диагностические критерии Лабораторный показатель Гемоглобин г/л Эритроциты х1012/л Нt % 5, 0 0, 8 4, 8 0, 6 47 5 42 5 Норма м ж 130 2 120 2 Диагностичес-кие критерии анемии м ж менее 130 менее 120 менее 4, 5 менее 4, 0 менее 42 менее 37
 Индексы эритроцитов Средний корпускулярный объем эритроцита MCV= гематокрит (%)х10 норма эритроциты(х1012/л) 80 -100 мкм 3 Среднее содержание гемоглобина в эритроците MCH = гемоглобин (г/дл)х10 норма эритроциты(х1012/л) 26 -34 п/г Средняя концентрация гемоглобина в эритроците MCHC = гемоглобин (г/дл)х100 норма гематокрит (%) 31 -37 г /100 мл крови
Индексы эритроцитов Средний корпускулярный объем эритроцита MCV= гематокрит (%)х10 норма эритроциты(х1012/л) 80 -100 мкм 3 Среднее содержание гемоглобина в эритроците MCH = гемоглобин (г/дл)х10 норма эритроциты(х1012/л) 26 -34 п/г Средняя концентрация гемоглобина в эритроците MCHC = гемоглобин (г/дл)х100 норма гематокрит (%) 31 -37 г /100 мл крови
 Морфологическая классификация анемий На основании оценки размеров эритроцитов (объема, диаметра, площади, толщины клетки), внутриклеточного содержания гемоглобина, построении кривой распределения эритроцитов по их объему все анемии делятся на Ø макроцитарные (средний объем эритроцитов >100 мкм 3) Ø нормоцитарные (средний объем эритроцитов 80 -100 мкм 3), Ø микроцитарные (средний объем эритроцитов <80 мкм 3).
Морфологическая классификация анемий На основании оценки размеров эритроцитов (объема, диаметра, площади, толщины клетки), внутриклеточного содержания гемоглобина, построении кривой распределения эритроцитов по их объему все анемии делятся на Ø макроцитарные (средний объем эритроцитов >100 мкм 3) Ø нормоцитарные (средний объем эритроцитов 80 -100 мкм 3), Ø микроцитарные (средний объем эритроцитов <80 мкм 3).
 Гипохромные микроцитарные анемии
Гипохромные микроцитарные анемии
 Железодефицитная анемия Синдром, характеризующийся снижением насыщения гемоглобина железом с последующим уменьшением содержания гемоглобина в эритроците. В результате несоответствия между поступлением и расходом (потреблением, потерей) развивается дефицит железа в сыворотке крови, костном мозге и депо, итогом чего является угнетение эритропоэза.
Железодефицитная анемия Синдром, характеризующийся снижением насыщения гемоглобина железом с последующим уменьшением содержания гемоглобина в эритроците. В результате несоответствия между поступлением и расходом (потреблением, потерей) развивается дефицит железа в сыворотке крови, костном мозге и депо, итогом чего является угнетение эритропоэза.
 Метаболические функции железа Железо – один из важнейших микроэлементов в организме Функция Соединение Окисление/ энергетический обмен Цитохромы a, b, c Цитохром Р 450 Каталаза, пероксидаза Транспорт кислорода Гемоглобин Миоглобин Дыхательная цепь митохондрий Сукцинатдегидрогеназа Инактивация свободных кислородных радикалов Ксантин оксидаза Синтез ДНК Рибонуклеотид редуктаза
Метаболические функции железа Железо – один из важнейших микроэлементов в организме Функция Соединение Окисление/ энергетический обмен Цитохромы a, b, c Цитохром Р 450 Каталаза, пероксидаза Транспорт кислорода Гемоглобин Миоглобин Дыхательная цепь митохондрий Сукцинатдегидрогеназа Инактивация свободных кислородных радикалов Ксантин оксидаза Синтез ДНК Рибонуклеотид редуктаза

 Распределение железа в организме поступление железа в организм = выведение железа из организма Потребление с пищей Утилизация Двенадцатиперстная кишка (1 -2 мг/сутки) Трансферрин плазмы (3 мг) Костный мозг (300 мг) Мышцы (миоглобин) (300 мг) Накопление железа Печень (1. 000 мг) Циркулирующие эритроциты (гемоглобин) (1. 800 мг) Слущивающиеся клетки слизистой оболочки Десквамация/менструации Другие кровопотери (в среднем 1 -2 мг в сутки) Потери железа Ретикулоэндотелиальные макрофаги (600 мг) Andrews NC, N Engl J Med 1999; 341: 1986 -1995
Распределение железа в организме поступление железа в организм = выведение железа из организма Потребление с пищей Утилизация Двенадцатиперстная кишка (1 -2 мг/сутки) Трансферрин плазмы (3 мг) Костный мозг (300 мг) Мышцы (миоглобин) (300 мг) Накопление железа Печень (1. 000 мг) Циркулирующие эритроциты (гемоглобин) (1. 800 мг) Слущивающиеся клетки слизистой оболочки Десквамация/менструации Другие кровопотери (в среднем 1 -2 мг в сутки) Потери железа Ретикулоэндотелиальные макрофаги (600 мг) Andrews NC, N Engl J Med 1999; 341: 1986 -1995
 КЛАССИФИКАЦИЯ ПО ТЯЖЕСТИ • ЖДА (ICMR): – легкой степени тяжести – Hb 100 - ниж. гран. нормы – средней – Hb 70 -99 г/л – тяжелой – Hb 40 -69 г/л – очень тяжелая - Hb < 40 г/л
КЛАССИФИКАЦИЯ ПО ТЯЖЕСТИ • ЖДА (ICMR): – легкой степени тяжести – Hb 100 - ниж. гран. нормы – средней – Hb 70 -99 г/л – тяжелой – Hb 40 -69 г/л – очень тяжелая - Hb < 40 г/л
 Гемовое и негемовое железо Продукты, богатые железом Тип железа Всасывание, % Телятина, говядина Гемоглобин, миоглобин 22 -25 Рыба, печень, почки Ферритин, гемосидерин 11 Яйца Ферритин, гемосидерин 3 Соевые бобы Элементарное 7 Яблоки, гранаты, гречка Элементарное < 3 Рис, шпинат Элементарное 1
Гемовое и негемовое железо Продукты, богатые железом Тип железа Всасывание, % Телятина, говядина Гемоглобин, миоглобин 22 -25 Рыба, печень, почки Ферритин, гемосидерин 11 Яйца Ферритин, гемосидерин 3 Соевые бобы Элементарное 7 Яблоки, гранаты, гречка Элементарное < 3 Рис, шпинат Элементарное 1
 Абсорбция негемового железа • Варьирует от 2 до 50% в зависимости от: – Состояния запасов Fe в организме – Растворимости соединений – Целостности слизистой кишечника – Наличие в пище ингибиторов и промоторов всасывания • Ингибиторы: – Полифенолы – злаки (овес), овощи (шпинат), специи и напитки (чай, кофе, какао, вино) – Фитат – отруби, пшеница, рис, бобовые (соя, горох) – Коровье молоко (Ca++, казеин) • Промоторы: – Аскорбиновая кислота – Мышечный протеин
Абсорбция негемового железа • Варьирует от 2 до 50% в зависимости от: – Состояния запасов Fe в организме – Растворимости соединений – Целостности слизистой кишечника – Наличие в пище ингибиторов и промоторов всасывания • Ингибиторы: – Полифенолы – злаки (овес), овощи (шпинат), специи и напитки (чай, кофе, какао, вино) – Фитат – отруби, пшеница, рис, бобовые (соя, горох) – Коровье молоко (Ca++, казеин) • Промоторы: – Аскорбиновая кислота – Мышечный протеин

 Хроническая кровопотеря Ø Из женских половых органов: гиперполименоррея ! - Дисфункциональные маточные кровотечения - Эндометриоз - Миома - Злокачественные новообразования - Внутриматочные контрацептивы
Хроническая кровопотеря Ø Из женских половых органов: гиперполименоррея ! - Дисфункциональные маточные кровотечения - Эндометриоз - Миома - Злокачественные новообразования - Внутриматочные контрацептивы
 Хроническая кровопотеря Ø Из органов желудочно-кишечного тракта: - эрозии и язвы желудка и 12 -перстной кишки - рак пищевода, желудка - эрозивный эзофагит - варикозное расширение вен пищевода и кардиального отдела желудка - грыжа пищеводного отверстия диафрагмы - неспецифический язвенный колит, болезнь Крона - рак толстого, иногда- тонкого кишечника - ангиоматозная дисплазия кишечника, болезнь Рандю-Ослера - дивертикулез, полипоз кишечника - геморрой, трещины, рак прямой кишки - глистные инвазии (анкилостомоз)
Хроническая кровопотеря Ø Из органов желудочно-кишечного тракта: - эрозии и язвы желудка и 12 -перстной кишки - рак пищевода, желудка - эрозивный эзофагит - варикозное расширение вен пищевода и кардиального отдела желудка - грыжа пищеводного отверстия диафрагмы - неспецифический язвенный колит, болезнь Крона - рак толстого, иногда- тонкого кишечника - ангиоматозная дисплазия кишечника, болезнь Рандю-Ослера - дивертикулез, полипоз кишечника - геморрой, трещины, рак прямой кишки - глистные инвазии (анкилостомоз)
 Хроническая кровопотеря Ø Из мочевыводящих путей: - мочекаменная болезнь - опухоли, туберкулез, поликистоз - болезнь Шейнляйн - Геноха - синдром Гудпасчера - пароксизмальная ночная гемоглобинурия - Ig A-нефропатия(болезнь Бурже)
Хроническая кровопотеря Ø Из мочевыводящих путей: - мочекаменная болезнь - опухоли, туберкулез, поликистоз - болезнь Шейнляйн - Геноха - синдром Гудпасчера - пароксизмальная ночная гемоглобинурия - Ig A-нефропатия(болезнь Бурже)
 Хроническая кровопотеря Ø Из органов дыхательной системы: - туберкулез - бронхоэктатическая болезнь - опухоли - изолированный легочный гемосидероз - синдром Гудпасчера - носовые кровотечения
Хроническая кровопотеря Ø Из органов дыхательной системы: - туберкулез - бронхоэктатическая болезнь - опухоли - изолированный легочный гемосидероз - синдром Гудпасчера - носовые кровотечения
 Нарушение всасывания Патология слизистой тонкой кишки: - энтериты различного происхождения - целиакия, спру - амилоидоз - болезнь Крона Ø Субтотальная гастрэктомия: - быстрое прохождение пищи через 12 -перстную кишку - ахлоргидрия (НСl способствует переходу 3 -х валентного железа в 2 -х валентное) - неудовлетворительная постгастрэктомическая диета Ø
Нарушение всасывания Патология слизистой тонкой кишки: - энтериты различного происхождения - целиакия, спру - амилоидоз - болезнь Крона Ø Субтотальная гастрэктомия: - быстрое прохождение пищи через 12 -перстную кишку - ахлоргидрия (НСl способствует переходу 3 -х валентного железа в 2 -х валентное) - неудовлетворительная постгастрэктомическая диета Ø
 Повышенная потребность Ø Период быстрого роста: - новорожденные - препубертатный и пубертатный период Ø Беременность (1100 мг) Ø Лактация (30 мг ежемесячно)
Повышенная потребность Ø Период быстрого роста: - новорожденные - препубертатный и пубертатный период Ø Беременность (1100 мг) Ø Лактация (30 мг ежемесячно)
 Недостаточное поступление с пищей При сбалансированном питании в сутки поступает до 20 мг железа, всасывается- 2, 53 мг. Ø У взрослого только 5% железа должно поступать извне, остальные 95% реутилизируются. Ø Чаще эта причина встречается у недоношенных детей, при многоплодной беременности, неправильном искусственном вскармливании, у пациентов с нервной анорексией. Ø
Недостаточное поступление с пищей При сбалансированном питании в сутки поступает до 20 мг железа, всасывается- 2, 53 мг. Ø У взрослого только 5% железа должно поступать извне, остальные 95% реутилизируются. Ø Чаще эта причина встречается у недоношенных детей, при многоплодной беременности, неправильном искусственном вскармливании, у пациентов с нервной анорексией. Ø
 Нарушение транспорта Ø Врожденная атрансферринемия Ø Появление антител к трансферрину Ø Гипопротеинемии различного генеза (нефротический синдром, цирроз печени, синдром мальабсорбции)
Нарушение транспорта Ø Врожденная атрансферринемия Ø Появление антител к трансферрину Ø Гипопротеинемии различного генеза (нефротический синдром, цирроз печени, синдром мальабсорбции)
 Три стадии развития дефицита железа I. Уменьшение количества резервного железа. Используется ферритин из макрофагов. Усиливается синтез трансферрина. II. Снижение железа сыворотки с истощением запасов. Снижается доставка железа в костный мозг, развивается микроцитоз, гипохромия. Повышается железо-связывающая способность сыворотки. Повышается синтез эритропоэтина и митотическая активность эритробластов. III. Анемия, неэффективный эритропоэз. Дефицит железа в миоглобине и ферментах.
Три стадии развития дефицита железа I. Уменьшение количества резервного железа. Используется ферритин из макрофагов. Усиливается синтез трансферрина. II. Снижение железа сыворотки с истощением запасов. Снижается доставка железа в костный мозг, развивается микроцитоз, гипохромия. Повышается железо-связывающая способность сыворотки. Повышается синтез эритропоэтина и митотическая активность эритробластов. III. Анемия, неэффективный эритропоэз. Дефицит железа в миоглобине и ферментах.
 Диагностика железодефицитной анемии Ø 63% больных ЖДА имеют симптомы анемии Ø 16% больных ЖДА имеют симптомы заболеваний, лежащих в основе анемии Ø 21% больных ЖДА не предъявляют жалоб и диагноз установлен при лабораторном исследовании
Диагностика железодефицитной анемии Ø 63% больных ЖДА имеют симптомы анемии Ø 16% больных ЖДА имеют симптомы заболеваний, лежащих в основе анемии Ø 21% больных ЖДА не предъявляют жалоб и диагноз установлен при лабораторном исследовании
 Сидеропенический синдром Органы-мишени при сидеропении: Ø Кожа, придатки кожи, слизистые Ø Желудочно-кишечный тракт Ø Нервная система Ø Сердечно-сосудистая система Ø Мышечная ткань
Сидеропенический синдром Органы-мишени при сидеропении: Ø Кожа, придатки кожи, слизистые Ø Желудочно-кишечный тракт Ø Нервная система Ø Сердечно-сосудистая система Ø Мышечная ткань
 Сидеропенический синдром Ø Специфическая бледность кожи с алебастровым оттенком Ø Симптом «голубых склер»
Сидеропенический синдром Ø Специфическая бледность кожи с алебастровым оттенком Ø Симптом «голубых склер»
 Бледность кожных покровов и слизистых у больных железодефицитной анемией 69 летняя женщина. Гемоглобин 81 г/л, Эритроциты 4, 13 х 1012/л, ЦП = 0, 6 гематокрит – 26, 8%, Средний объем эритроцитов – 65 мкм 3, среднее содержание Hb в эритроците 19, 6 пг.
Бледность кожных покровов и слизистых у больных железодефицитной анемией 69 летняя женщина. Гемоглобин 81 г/л, Эритроциты 4, 13 х 1012/л, ЦП = 0, 6 гематокрит – 26, 8%, Средний объем эритроцитов – 65 мкм 3, среднее содержание Hb в эритроците 19, 6 пг.
 Сидеропенический синдром Ø Ломкость, слоистость ногтей, их поперечная исчерченность, уплощение, тусклость, ложкообразная форма, невозможность отрастить длинные ногти. Ø Расслаивание кончиков волос, волосы секутся, невозможно отрастить длинные волосы.
Сидеропенический синдром Ø Ломкость, слоистость ногтей, их поперечная исчерченность, уплощение, тусклость, ложкообразная форма, невозможность отрастить длинные ногти. Ø Расслаивание кончиков волос, волосы секутся, невозможно отрастить длинные волосы.
 Железодефицитная анемия Бледность, тусклость ногтевого ложа у пациента со смуглой кожей
Железодефицитная анемия Бледность, тусклость ногтевого ложа у пациента со смуглой кожей
 Железодефицитная анемия. Койлонихии Вогнутые, истонченные, ломкие
Железодефицитная анемия. Койлонихии Вогнутые, истонченные, ломкие
 Сидеропенический синдром Ø Сухость, истонченность, легкая травматизация кожи, нарушение целостности эпидермиса (ангулярный стоматит или «заеды» в углах рта. Ø Глоссит, сглаженность сосочков, трещины, чувство жжения языка.
Сидеропенический синдром Ø Сухость, истонченность, легкая травматизация кожи, нарушение целостности эпидермиса (ангулярный стоматит или «заеды» в углах рта. Ø Глоссит, сглаженность сосочков, трещины, чувство жжения языка.
 Железодефицитная анемия
Железодефицитная анемия
 Железодефицитная анемия
Железодефицитная анемия
 Сидеропенический синдром Ø Атрофические изменения слизистой оболочки желудочно - кишечного тракта: сухость слизистой оболочки, затруднения и боли при глотании (сидеропеническая дисфагия или синдром Пламмера-Винсона). Развитие атрофического гастрита и энтерита.
Сидеропенический синдром Ø Атрофические изменения слизистой оболочки желудочно - кишечного тракта: сухость слизистой оболочки, затруднения и боли при глотании (сидеропеническая дисфагия или синдром Пламмера-Винсона). Развитие атрофического гастрита и энтерита.
 Синдром сидеропенической дисфагии (синдром Пламмера-Винсона) Атрофия слизистой полости рта, глотки, пищевода с дисфагией: расстройства глотания, чувство жжения в языке, спазм пищевода.
Синдром сидеропенической дисфагии (синдром Пламмера-Винсона) Атрофия слизистой полости рта, глотки, пищевода с дисфагией: расстройства глотания, чувство жжения в языке, спазм пищевода.
 Сидеропенический синдром Извращение вкуса: непреодолимое желание употребить в пищу что-либо необычное и малосъедобное (мел, зубной порошок, уголь, глину, сырые крупы и макаронные изделия, сырое тесто, фарш) Ø Пристрастие к острой, соленой, кислой, пряной пище Ø Извращение обоняния: пристрастие к неприятным запахам (бензин, керосин, ацетон, лаки, краски, нафталин, гуталин) Ø
Сидеропенический синдром Извращение вкуса: непреодолимое желание употребить в пищу что-либо необычное и малосъедобное (мел, зубной порошок, уголь, глину, сырые крупы и макаронные изделия, сырое тесто, фарш) Ø Пристрастие к острой, соленой, кислой, пряной пище Ø Извращение обоняния: пристрастие к неприятным запахам (бензин, керосин, ацетон, лаки, краски, нафталин, гуталин) Ø
 Сидеропенический синдром Ø Невозможность удержать мочу при кашле, смехе, чихании Ø Ночное недержание мочи
Сидеропенический синдром Ø Невозможность удержать мочу при кашле, смехе, чихании Ø Ночное недержание мочи
Микроцитоз, гипохромия Нормальные эритроциты
Микроцитоз, гипохромия Нормальные эритроциты
 Принципы лечения железодефицитной анемии Устранение причины анемии Ø Заместительная терапия препаратами железа - лечение анемии ( 4 -8 недель) - насыщающая терапия (3 -6 месяцев) - поддерживающая терапия Ø
Принципы лечения железодефицитной анемии Устранение причины анемии Ø Заместительная терапия препаратами железа - лечение анемии ( 4 -8 недель) - насыщающая терапия (3 -6 месяцев) - поддерживающая терапия Ø
 Необходимая суточная доза железа для лечения ЖДА в зависимости от возраста Ø Новорожденные 3 мг/кг Ø Дети 1 -3 лет 5 -8 мг/кг Ø Дети 4 -16 лет 100 -120 мг/сут Ø Взрослые 200 -300 мг/сут
Необходимая суточная доза железа для лечения ЖДА в зависимости от возраста Ø Новорожденные 3 мг/кг Ø Дети 1 -3 лет 5 -8 мг/кг Ø Дети 4 -16 лет 100 -120 мг/сут Ø Взрослые 200 -300 мг/сут
 Принципы лечения ЖДА Ø Ø Ø Невозможно устранить ЖДА без препаратов железа, лишь диетой При ЖДА не следует прибегать к трансфузиям эритроцитов без жизненных показаний ЖДА следует лечить препаратами Fe, а не витаминами группы В ЖДА следует лечить в основном препаратами для приема внутрь Достижения нормального уровня Hb не повод останавливать лечение. Для насыщения депо железом длительность терапии должна составить 3 -6 мес.
Принципы лечения ЖДА Ø Ø Ø Невозможно устранить ЖДА без препаратов железа, лишь диетой При ЖДА не следует прибегать к трансфузиям эритроцитов без жизненных показаний ЖДА следует лечить препаратами Fe, а не витаминами группы В ЖДА следует лечить в основном препаратами для приема внутрь Достижения нормального уровня Hb не повод останавливать лечение. Для насыщения депо железом длительность терапии должна составить 3 -6 мес.
 Парентерально препараты железа могут применяться при следующих клинических ситуациях: нарушение всасывания при патологии кишечника (энтериты, резекция тонкой кишки и желудка, синдром мальабсорбции), Ø выраженная желудочная и кишечная диспепсия Ø проведение гемодиализа Ø нарушение глотания Ø
Парентерально препараты железа могут применяться при следующих клинических ситуациях: нарушение всасывания при патологии кишечника (энтериты, резекция тонкой кишки и желудка, синдром мальабсорбции), Ø выраженная желудочная и кишечная диспепсия Ø проведение гемодиализа Ø нарушение глотания Ø
 Принципы лечения ЖДА (2) Старт терапии препаратом Fe р. о. Ø Через 4 недели общий анализ крови: Ø – Ø Повышение уровня Hb не менее чем, на 10 г/л или Ht на 3% от исходного подтверждает диагноз ЖДА, в противном случае пересмотреть диагноз! Продолжить терапию еще 2 мес. и повторно оценить эффект (Hb, Ht, MCV, MCH, RDW + биохимия – Fe, ОЖСС, ферритин): – – Норма → остановить лечение или перевести на поддерживающую терапию (женщины) Не нормализовались → продлить до 6 мес.
Принципы лечения ЖДА (2) Старт терапии препаратом Fe р. о. Ø Через 4 недели общий анализ крови: Ø – Ø Повышение уровня Hb не менее чем, на 10 г/л или Ht на 3% от исходного подтверждает диагноз ЖДА, в противном случае пересмотреть диагноз! Продолжить терапию еще 2 мес. и повторно оценить эффект (Hb, Ht, MCV, MCH, RDW + биохимия – Fe, ОЖСС, ферритин): – – Норма → остановить лечение или перевести на поддерживающую терапию (женщины) Не нормализовались → продлить до 6 мес.
 Потребность в железе во время беременности Ø Ø Ø дополнительные эритроциты беременной женщины 450 мг; на ткани плода, пуповины и плаценты 360 мг; потеря крови в родах 200 -250 мг; обычные потери с потом и через ЖКТ 1 мг в день; потери с лактацией 1 мг в день. ВСЕГО: более 1000 мг
Потребность в железе во время беременности Ø Ø Ø дополнительные эритроциты беременной женщины 450 мг; на ткани плода, пуповины и плаценты 360 мг; потеря крови в родах 200 -250 мг; обычные потери с потом и через ЖКТ 1 мг в день; потери с лактацией 1 мг в день. ВСЕГО: более 1000 мг
 Критерии анемии у беременных женщин I и III триместры гемоглобин < 110 г/л Ø II триместр гемоглобин < 105 г/л Ø
Критерии анемии у беременных женщин I и III триместры гемоглобин < 110 г/л Ø II триместр гемоглобин < 105 г/л Ø
 Акушерский анамнез и содержание ферритина сыворотки у женщин (V. G. Unoe, 1994) Акушерский анамнез Ферритин сыворотки (мкг/л) Не было беременностей 38 Одна беременность и более 2 лет назад 28 Одна беременность и только 1 год назад 20 Две беременности и последняя до 12 месяцев назад 15
Акушерский анамнез и содержание ферритина сыворотки у женщин (V. G. Unoe, 1994) Акушерский анамнез Ферритин сыворотки (мкг/л) Не было беременностей 38 Одна беременность и более 2 лет назад 28 Одна беременность и только 1 год назад 20 Две беременности и последняя до 12 месяцев назад 15
 Послеродовая анемия. Эпидемиология Ø У 30% женщин после родов выявляют гемоглобин менее 100 г/л Ø У 10% женщин после родов выявляют гемоглобин менее 80 г/л
Послеродовая анемия. Эпидемиология Ø У 30% женщин после родов выявляют гемоглобин менее 100 г/л Ø У 10% женщин после родов выявляют гемоглобин менее 80 г/л
 Послеродовая анемия. Причины Ø Истощение запасов железа в депо в процессе беременности. Ø Потеря крови во время родов.
Послеродовая анемия. Причины Ø Истощение запасов железа в депо в процессе беременности. Ø Потеря крови во время родов.
 Потеря крови после родов Ø Физиологические роды: 400 -500 мл крови (200 -250 мг железа). Ø Кесарево сечение: 900 мл крови (450 мг железа). Ø Многоплодная беременность: 900 мл крови (450 мг железа).
Потеря крови после родов Ø Физиологические роды: 400 -500 мл крови (200 -250 мг железа). Ø Кесарево сечение: 900 мл крови (450 мг железа). Ø Многоплодная беременность: 900 мл крови (450 мг железа).
 Профилактика и лечение ЖДА при беременности Цель: Hb 110 -120 г/л, Ht 33 -36% Ø В случае диагностированной ЖДА целесообразно давать Fe р. о на протяжении всего 2 и 3 -го триместра беременности Ø Рутинная профилактика в развитых странах не проводится, в развивающихся (Индия, Африка) рекомендуется Ø Контроль: ретикулоциты 3 -7 день Ø Гемограмма: через 2 -3 нед. значимое повышение Hb Ø
Профилактика и лечение ЖДА при беременности Цель: Hb 110 -120 г/л, Ht 33 -36% Ø В случае диагностированной ЖДА целесообразно давать Fe р. о на протяжении всего 2 и 3 -го триместра беременности Ø Рутинная профилактика в развитых странах не проводится, в развивающихся (Индия, Африка) рекомендуется Ø Контроль: ретикулоциты 3 -7 день Ø Гемограмма: через 2 -3 нед. значимое повышение Hb Ø
 Патофизиология ЖДА у плода Ø Слабая и умеренная анемия не оказывает значимого влияния на плод l l Ø Активный транспорт Fe через плаценту Уровень Fe и ферритина у плода в 3 раза выше чем у матери Тяжелая анемия приводит: l Внутриутробной задержке развития и даже гибели плода l Недоношенности l Аномальной инвазии трофобласта l Патологии внутриутробного развития и болезням новорожденных
Патофизиология ЖДА у плода Ø Слабая и умеренная анемия не оказывает значимого влияния на плод l l Ø Активный транспорт Fe через плаценту Уровень Fe и ферритина у плода в 3 раза выше чем у матери Тяжелая анемия приводит: l Внутриутробной задержке развития и даже гибели плода l Недоношенности l Аномальной инвазии трофобласта l Патологии внутриутробного развития и болезням новорожденных
 Показания к трансфузиям компонентов крови Ø К трансфузиям следует прибегать только если нет других способов лечения (рекомендации ВОЗ) Ø Показания к гемотрансфузионной терапии: м l Тяжелая анемия в 3 триместре l Тяжелая застойная сердечная недостаточность l Острая кровопотеря или гемолиз у беременных
Показания к трансфузиям компонентов крови Ø К трансфузиям следует прибегать только если нет других способов лечения (рекомендации ВОЗ) Ø Показания к гемотрансфузионной терапии: м l Тяжелая анемия в 3 триместре l Тяжелая застойная сердечная недостаточность l Острая кровопотеря или гемолиз у беременных
 Риски гемотрансфузионной терапии Гемолитические реакции – 1 : 40 000 Ø Не гемолитические фебрильные реакции – 3 -4% Ø Анафилактические реакции – 1 : 20 000 Ø Ø Ø РТПХ – 0, 1 -1% СОППЛ – 0, 1 -0, 2% HBV 1 : 50 000 HCV 1 : 3 000 ВИЧ 1 : 150 000 Данные по США, 2001
Риски гемотрансфузионной терапии Гемолитические реакции – 1 : 40 000 Ø Не гемолитические фебрильные реакции – 3 -4% Ø Анафилактические реакции – 1 : 20 000 Ø Ø Ø РТПХ – 0, 1 -1% СОППЛ – 0, 1 -0, 2% HBV 1 : 50 000 HCV 1 : 3 000 ВИЧ 1 : 150 000 Данные по США, 2001
 Препараты железа Ø Для р. о. применения: l 2 -х валентное Fe – приоритетные препараты для лечения ЖДА (тотема, сорбифер, актиферрин …)! l 3 -х валентное Fe (мальтофер, феррум-лек) Ø Для парентерального использования: l Декстраны Fe (венофер, феринжект, космофер)
Препараты железа Ø Для р. о. применения: l 2 -х валентное Fe – приоритетные препараты для лечения ЖДА (тотема, сорбифер, актиферрин …)! l 3 -х валентное Fe (мальтофер, феррум-лек) Ø Для парентерального использования: l Декстраны Fe (венофер, феринжект, космофер)
 ВСАСЫВАЕМОСТЬ СОЛЕВЫХ ПРЕПАРАТОВ ЖЕЛЕЗА ВЫСОКАЯ Сульфат Глюконат Хлорид Фумарат НИЗКАЯ
ВСАСЫВАЕМОСТЬ СОЛЕВЫХ ПРЕПАРАТОВ ЖЕЛЕЗА ВЫСОКАЯ Сульфат Глюконат Хлорид Фумарат НИЗКАЯ
 Современные препараты двухвалентного железа. Пероральные лекарственные формы Препараты двухвалентного железа Сульфат железа: Актиферрин, Гемофер пролонгатум, Сорбифер Дурулес, Тардиферон, Ферроплекс, Ферроградумет, Ферро. Фольгамма Глюконат железа: Тотема, Апо-Ферроглюконат Хлорид железа: Гемофер Фумарат железа: Ферретаб комп. , Железа фумарат 200, Ферронат
Современные препараты двухвалентного железа. Пероральные лекарственные формы Препараты двухвалентного железа Сульфат железа: Актиферрин, Гемофер пролонгатум, Сорбифер Дурулес, Тардиферон, Ферроплекс, Ферроградумет, Ферро. Фольгамма Глюконат железа: Тотема, Апо-Ферроглюконат Хлорид железа: Гемофер Фумарат железа: Ферретаб комп. , Железа фумарат 200, Ферронат
 Оценка эффективности терапии железо-дефицитной анемии 7 -10 -й день – увеличение ретикулоцитов в крови 3 -4 -я неделя – прирост гемоглобина и числа эритроцитов 4 -8 -я неделя – исчезновение гипохромии и микроцитоза, нормализация показателей красной крови 3 -6 месяц – нормализация показателей качества жизни
Оценка эффективности терапии железо-дефицитной анемии 7 -10 -й день – увеличение ретикулоцитов в крови 3 -4 -я неделя – прирост гемоглобина и числа эритроцитов 4 -8 -я неделя – исчезновение гипохромии и микроцитоза, нормализация показателей красной крови 3 -6 месяц – нормализация показателей качества жизни
 Анемии хронических заболеваний Ø Хронические инфекции: остеомелит, туберкулез, бронхоэктатическая болезнь, инфекционный эндокардит, абсцесс легкого. Ø Системные заболевания: СКВ, ревматоидный артрит, узелковый периартериит, болезнь Крона. Ø Злокачественные новообразования.
Анемии хронических заболеваний Ø Хронические инфекции: остеомелит, туберкулез, бронхоэктатическая болезнь, инфекционный эндокардит, абсцесс легкого. Ø Системные заболевания: СКВ, ревматоидный артрит, узелковый периартериит, болезнь Крона. Ø Злокачественные новообразования.
 Анемии хронических заболеваний Под влиянием бактериальных эндотоксинов, цитокинов, опухолевых клеток, происходит активация макрофагов с последущим выделением ими IL-1 и TNF, в результате чего подавляется эритропоэтическая активность костного мозга. Ø Макрофаги депонируют железо с трасферрином без вторичного его высвобождения. Ø
Анемии хронических заболеваний Под влиянием бактериальных эндотоксинов, цитокинов, опухолевых клеток, происходит активация макрофагов с последущим выделением ими IL-1 и TNF, в результате чего подавляется эритропоэтическая активность костного мозга. Ø Макрофаги депонируют железо с трасферрином без вторичного его высвобождения. Ø
 Критерии диагноза Хроническое воспаление или новообразование Ø Низкий или нормальный уровень Fe сыворотки с пониженной ОЖСС и насыщением трансферрина железом менее чем 15%. Ø Нормальный или повышенный уровень ферритина сыворотки. Ø Достаточное количество гранул гемосидерина в костномозговых макрофагах. Ø
Критерии диагноза Хроническое воспаление или новообразование Ø Низкий или нормальный уровень Fe сыворотки с пониженной ОЖСС и насыщением трансферрина железом менее чем 15%. Ø Нормальный или повышенный уровень ферритина сыворотки. Ø Достаточное количество гранул гемосидерина в костномозговых макрофагах. Ø
 Гиперхромные макроцитарные анемии
Гиперхромные макроцитарные анемии
 Витамин В 12 -дефицитная анемия Первое описание Thomas Addison - 1849 г. Анемия Аддисона – Бирмера ( пернициозная, “злокачественная анемия” ) Распространенность 0, 1% населения молодого возраста 1% населения после 50 лет 4% населения после 75 лет
Витамин В 12 -дефицитная анемия Первое описание Thomas Addison - 1849 г. Анемия Аддисона – Бирмера ( пернициозная, “злокачественная анемия” ) Распространенность 0, 1% населения молодого возраста 1% населения после 50 лет 4% населения после 75 лет
 Дефицит «внутреннего фактора» Фермент, переводящий неактивную форму витамина B 12, (поступающую с пищей) в активную (усвояемую). Одноцепочечный гликопротеин, состоящий из 340 аминокислотных остатков. Мукоидная часть комплекса защищает его от гидролиза пищеварительными ферментами и утилизации бактериями кишечника; белковая часть определяет его физиологическую активность. Основная роль внутреннего фактора Касла заключается в образовании с вит В 12 лабильного комплекса, который всасывается эпителиальными клетками подвздошной кишки. Ø Ø Ø Атрофический гастрит Антитела к париетальным клеткам Антитела к внутреннему фактору Тотальная резекция желудка Рак желудка Наследственное нарушение синтеза внутреннего фактора
Дефицит «внутреннего фактора» Фермент, переводящий неактивную форму витамина B 12, (поступающую с пищей) в активную (усвояемую). Одноцепочечный гликопротеин, состоящий из 340 аминокислотных остатков. Мукоидная часть комплекса защищает его от гидролиза пищеварительными ферментами и утилизации бактериями кишечника; белковая часть определяет его физиологическую активность. Основная роль внутреннего фактора Касла заключается в образовании с вит В 12 лабильного комплекса, который всасывается эпителиальными клетками подвздошной кишки. Ø Ø Ø Атрофический гастрит Антитела к париетальным клеткам Антитела к внутреннему фактору Тотальная резекция желудка Рак желудка Наследственное нарушение синтеза внутреннего фактора
 Нарушение всасывания в тонкой кишке Ø Резекция участка тонкой кишки более 60 см Ø Синдром мальабсорбции различного генеза Ø Рак, лимфома тонкой кишки Ø Врожденное отсутствие рецеторов на энтероцитах Ø Влияние лекарственных средств (колхицин, бигуаниды, ПАСК)
Нарушение всасывания в тонкой кишке Ø Резекция участка тонкой кишки более 60 см Ø Синдром мальабсорбции различного генеза Ø Рак, лимфома тонкой кишки Ø Врожденное отсутствие рецеторов на энтероцитах Ø Влияние лекарственных средств (колхицин, бигуаниды, ПАСК)
 Повышенный расход Ø Беременность Ø Хроническая гемолитическая анемия Ø Новообразования Ø Тиреотоксикоз
Повышенный расход Ø Беременность Ø Хроническая гемолитическая анемия Ø Новообразования Ø Тиреотоксикоз
 Другие причины Конкурентное расходование (инвазия широким лентецом, дивертикулы тонкого кишечника с дивертикулитом) Ø Вегетарианство Ø Цирроз печени (снижение запасов) Ø Нарушение транспорта (врожденная атранскобаламинемия, антитела к транскобаламину ll) Ø Злоупотрение оксидом азота (окисление атома кобальта) Ø
Другие причины Конкурентное расходование (инвазия широким лентецом, дивертикулы тонкого кишечника с дивертикулитом) Ø Вегетарианство Ø Цирроз печени (снижение запасов) Ø Нарушение транспорта (врожденная атранскобаламинемия, антитела к транскобаламину ll) Ø Злоупотрение оксидом азота (окисление атома кобальта) Ø
 Патогенез метилкобаламин ФК ТГФК синтез ДНК дезоксиаденозилкобаламин метилмалоновая к-та янтарная к-та синтез жирных к-т
Патогенез метилкобаламин ФК ТГФК синтез ДНК дезоксиаденозилкобаламин метилмалоновая к-та янтарная к-та синтез жирных к-т
 Патогенез Нарушение синтеза тимидина –страдают быстрорастущие ткани: - костный мозг - эпителий желудочно-кишечного тракта Ø Нарушение обмена жирных кислот – поражение нервной системы: - нарушение синтеза миелина - повреждение задних и боковых столбов спинного мозга - прямое токсическое действие метилмалоновой кислоты Ø
Патогенез Нарушение синтеза тимидина –страдают быстрорастущие ткани: - костный мозг - эпителий желудочно-кишечного тракта Ø Нарушение обмена жирных кислот – поражение нервной системы: - нарушение синтеза миелина - повреждение задних и боковых столбов спинного мозга - прямое токсическое действие метилмалоновой кислоты Ø
 Первые клинические проявления у больных с В 12 -дефицитной анемией (G. R. Lee, 1999) Симптомы анемии 58% Парестезии 13% Жалобы со стороны желудочно- 11% кишечного тракта Болезненность языка и/или 7% слизистой полост рта Потеря веса 5% Нарушения походки 3% Другие 3%
Первые клинические проявления у больных с В 12 -дефицитной анемией (G. R. Lee, 1999) Симптомы анемии 58% Парестезии 13% Жалобы со стороны желудочно- 11% кишечного тракта Болезненность языка и/или 7% слизистой полост рта Потеря веса 5% Нарушения походки 3% Другие 3%
 Поражение пищеварительной системы Ø Глоссит: гладкий «лакированный» язык с атрофией сосочков, потрескавшийся, с участками воспаления ярко- красного цвета Ø Атрофический гастрит Ø Атрофия слизистой кишечника
Поражение пищеварительной системы Ø Глоссит: гладкий «лакированный» язык с атрофией сосочков, потрескавшийся, с участками воспаления ярко- красного цвета Ø Атрофический гастрит Ø Атрофия слизистой кишечника
 Мегалобластная анемия Глоссит –увеличенный малиновый язык, лакированный язык, болезненный, чувствительный к горячему и кислому Ангулярный хеилит
Мегалобластная анемия Глоссит –увеличенный малиновый язык, лакированный язык, болезненный, чувствительный к горячему и кислому Ангулярный хеилит
 Поражение кроветворной системы Ø Анемический синдром, связанный с основным заболеванием, а также компонентом гемолиза Ø Тромбоцитопения Ø Лейкопения, гиперсегментация ядер нейтрофилов Ø Ретикулоцитопения
Поражение кроветворной системы Ø Анемический синдром, связанный с основным заболеванием, а также компонентом гемолиза Ø Тромбоцитопения Ø Лейкопения, гиперсегментация ядер нейтрофилов Ø Ретикулоцитопения
 Мегалобластное кроветворение
Мегалобластное кроветворение
 Поражение нервной ситемы Ø Фуникулярный миелоз: демиелинизация, а затем дегенерация нервных волокон в спинном мозге и в спинномозговых нервах. Ø Клиника: слабость в ногах, ощущения ползанья мурашек, онемение ног, снижение сухожильных рефлексов, парапарезы, нарушение функции тазовых органов
Поражение нервной ситемы Ø Фуникулярный миелоз: демиелинизация, а затем дегенерация нервных волокон в спинном мозге и в спинномозговых нервах. Ø Клиника: слабость в ногах, ощущения ползанья мурашек, онемение ног, снижение сухожильных рефлексов, парапарезы, нарушение функции тазовых органов
 Основные диагностические критерии 1. 2. 3. 4. 5. 6. 7. 8. Гиперхромный характер анемии Характерные изменения эритроцитов: - макроцитоз (увеличение диаметра) - тельца Жолли, кольца Кебота(остатки ядер) Лейкопения Тромбоцитопения Ретикулоцитопения Мегалобластное кроветворение в миелограмме Низкая концентрация витамина В 12 в сыворотке Наличие клиники фуникулярного миелоза
Основные диагностические критерии 1. 2. 3. 4. 5. 6. 7. 8. Гиперхромный характер анемии Характерные изменения эритроцитов: - макроцитоз (увеличение диаметра) - тельца Жолли, кольца Кебота(остатки ядер) Лейкопения Тромбоцитопения Ретикулоцитопения Мегалобластное кроветворение в миелограмме Низкая концентрация витамина В 12 в сыворотке Наличие клиники фуникулярного миелоза
 Дополнительные диагностические критерии Атрофический гастрит 2. Обнаружение антител к париетальным клеткам, внутреннему фактору 3. Повышение концентрации метилмалоновой кислоты в моче 4. Положительный результат пробной терапии витамином В 12 (ретикулоцитарный криз на 7 -е сутки) 1.
Дополнительные диагностические критерии Атрофический гастрит 2. Обнаружение антител к париетальным клеткам, внутреннему фактору 3. Повышение концентрации метилмалоновой кислоты в моче 4. Положительный результат пробной терапии витамином В 12 (ретикулоцитарный криз на 7 -е сутки) 1.
 Лечение В 12 -дефицитной анемии Устранение причины (если возможно) Цианкобаламин или гидроксикобаламин 500 - 1000 мкг/сутки в/м ежедневно 7 дней, затем, при увеличении ретикулоцитов в крови, в той же дозе 3 -4 раза в неделю в течение 2 -х недель, затем 1 раз в неделю 4 -6 недель. При выраженной неврологической симптоматике 500 -1000 мкг/сутки в/м или в/в. Поддерживающая терапия – 200 мкг/сутки 5 -7 дней 2 раза в год.
Лечение В 12 -дефицитной анемии Устранение причины (если возможно) Цианкобаламин или гидроксикобаламин 500 - 1000 мкг/сутки в/м ежедневно 7 дней, затем, при увеличении ретикулоцитов в крови, в той же дозе 3 -4 раза в неделю в течение 2 -х недель, затем 1 раз в неделю 4 -6 недель. При выраженной неврологической симптоматике 500 -1000 мкг/сутки в/м или в/в. Поддерживающая терапия – 200 мкг/сутки 5 -7 дней 2 раза в год.
 Показатели нормального обмена фолиевой кислоты Суточная потребность – 100 - 200 мкг Ø C пищей поступает 500 -600 мкг/сут Ø Общее содержание фолатов в организме 5 - 10 мг Ø Депо фолатов (печень) – 2, 5 - 5 мг, запас на 4 - 5 мес. Ø Суточная экскреция с мочой- менее 10 нг Ø Содержание фолатов в сыворотке 6 - 20 нг/мл Ø Содержание фолатов в эритроцитах 160 - 640 нг/мл Ø
Показатели нормального обмена фолиевой кислоты Суточная потребность – 100 - 200 мкг Ø C пищей поступает 500 -600 мкг/сут Ø Общее содержание фолатов в организме 5 - 10 мг Ø Депо фолатов (печень) – 2, 5 - 5 мг, запас на 4 - 5 мес. Ø Суточная экскреция с мочой- менее 10 нг Ø Содержание фолатов в сыворотке 6 - 20 нг/мл Ø Содержание фолатов в эритроцитах 160 - 640 нг/мл Ø
 Причины дефицита фолиевой кислоты Недостаточное поступление с пищей Ø Нарушение всасывания в тонком кишечнике Ø Повышенная потребность (беременные, при хроническом гемолизе, эксфолиативном дерматите, злокачественных новообразованиях) Ø Повышенная потеря (гемодиализ, цирроз печени, псориаз, почечная недостаточность) Ø
Причины дефицита фолиевой кислоты Недостаточное поступление с пищей Ø Нарушение всасывания в тонком кишечнике Ø Повышенная потребность (беременные, при хроническом гемолизе, эксфолиативном дерматите, злокачественных новообразованиях) Ø Повышенная потеря (гемодиализ, цирроз печени, псориаз, почечная недостаточность) Ø
 Причины дефицита фолиевой кислоты Прием лекарственных препаратов: -Снижающих всасывание фолиевой кислоты: дифенин, фенобарбитал бигуаниды -Угнетающие активность основых ферментов, участвующих в метаболизме фолиевой кислоты: бисептол метотрексат триамтерен Ø Злоупотребление алкоголем Ø
Причины дефицита фолиевой кислоты Прием лекарственных препаратов: -Снижающих всасывание фолиевой кислоты: дифенин, фенобарбитал бигуаниды -Угнетающие активность основых ферментов, участвующих в метаболизме фолиевой кислоты: бисептол метотрексат триамтерен Ø Злоупотребление алкоголем Ø
 Клиническая симптоматика фолиеводефицитной анемии Клинические проявления как при В 12 дефицитной анемии кроме неврологической симптоматики (исключение – алкогольная полинейропатия)
Клиническая симптоматика фолиеводефицитной анемии Клинические проявления как при В 12 дефицитной анемии кроме неврологической симптоматики (исключение – алкогольная полинейропатия)
 Лечение фолиеводефицитной анемии Фолиевая кислота 15 – 20 мг/сутки per os в течение 30 дней Редко - кальция фолинат (лейковорин) в/в или в/м 5 -20 мг/сутки Комбинированные препараты
Лечение фолиеводефицитной анемии Фолиевая кислота 15 – 20 мг/сутки per os в течение 30 дней Редко - кальция фолинат (лейковорин) в/в или в/м 5 -20 мг/сутки Комбинированные препараты
 Гемолитические анемии
Гемолитические анемии
 Подходы к классификации Врожденные Иммунные Внутрисосудистые Приобретенные Неиммунные Внесосудистые
Подходы к классификации Врожденные Иммунные Внутрисосудистые Приобретенные Неиммунные Внесосудистые
 Классификация гемолитических анемий в зависимости от типа дефекта Врожденные Дефект мембраны эритроцитов: микросфероцитоз эллипсоцитоз Дефект метаболизма: дефицит глюкозо-6 -фосфатдегидрогеназы дефицит пируваткиназы Гемоглобинопатии талассемия серповидноклеточная анемия
Классификация гемолитических анемий в зависимости от типа дефекта Врожденные Дефект мембраны эритроцитов: микросфероцитоз эллипсоцитоз Дефект метаболизма: дефицит глюкозо-6 -фосфатдегидрогеназы дефицит пируваткиназы Гемоглобинопатии талассемия серповидноклеточная анемия
 Приобретенные Иммунологические дефекты гемолиз, индуцированный лекарствами изоиммунный и аллоиммунный гемолиз (неонатальный и отсроченные трансфузионные реакции) Механический дефект быстрый турбулентный ток крови злокачественная гипертензия критический аортальный стеноз несостоятельность протеза клапана внутрисосудистая коагулопатия (ДВС, тромботическая тромбоцитопеническая пурпура) маршевая гемоглобинурия Инфекции эндотоксины при бактериальных инфекциях паразитарные инфекции малярия (Plasmodium) Bartonella bacilliformis ( лихорадка Oroya) Аномалии мембраны ( патология стволовой клетки) пароксизмальная ночная гемоглобинурия
Приобретенные Иммунологические дефекты гемолиз, индуцированный лекарствами изоиммунный и аллоиммунный гемолиз (неонатальный и отсроченные трансфузионные реакции) Механический дефект быстрый турбулентный ток крови злокачественная гипертензия критический аортальный стеноз несостоятельность протеза клапана внутрисосудистая коагулопатия (ДВС, тромботическая тромбоцитопеническая пурпура) маршевая гемоглобинурия Инфекции эндотоксины при бактериальных инфекциях паразитарные инфекции малярия (Plasmodium) Bartonella bacilliformis ( лихорадка Oroya) Аномалии мембраны ( патология стволовой клетки) пароксизмальная ночная гемоглобинурия
 Внутриклеточный Внутрисосудистый гемолиз 1. 2. 3. 4. Аутоиммуный гемолиз с тепловыми агглютининами Наследственные мембранопатии Гемоглобинопатии (талассемии) Некоторые наследственные ферментопатии 1. 2. 3. 4. 5. 6. 7. Травматический гемолиз Дефицит глюкозо-6 фосфатдегидрогеназы Переливание несовместимой крови Пароксизмальная ночная гемоглобинурия Пароксизмальная холодовая гемоглобинурия Аутоиммунный гемолиз с тепловыми гемолизинами Аутоиммунный гемолиз с холодовыми агглютининами
Внутриклеточный Внутрисосудистый гемолиз 1. 2. 3. 4. Аутоиммуный гемолиз с тепловыми агглютининами Наследственные мембранопатии Гемоглобинопатии (талассемии) Некоторые наследственные ферментопатии 1. 2. 3. 4. 5. 6. 7. Травматический гемолиз Дефицит глюкозо-6 фосфатдегидрогеназы Переливание несовместимой крови Пароксизмальная ночная гемоглобинурия Пароксизмальная холодовая гемоглобинурия Аутоиммунный гемолиз с тепловыми гемолизинами Аутоиммунный гемолиз с холодовыми агглютининами
 Внутриклеточный гемолиз 1. Желтуха, не сопровождающая кожным зудом, бледность 2. Нормохромная анемия 3. Увеличение ретикулоцитов крови 4. Наличие в крови ядросодержащих эритроидных клеток 5. Раздражение эритроидного ростка 6. Непрямая гипербилирубинемия 7. Моча цвета темного пива, уробилин (желчные пигменты)++++ 8. Плейхромия кала 9. Увеличение селезенки 10. Укорочение продолжительности жизни эритроцитов
Внутриклеточный гемолиз 1. Желтуха, не сопровождающая кожным зудом, бледность 2. Нормохромная анемия 3. Увеличение ретикулоцитов крови 4. Наличие в крови ядросодержащих эритроидных клеток 5. Раздражение эритроидного ростка 6. Непрямая гипербилирубинемия 7. Моча цвета темного пива, уробилин (желчные пигменты)++++ 8. Плейхромия кала 9. Увеличение селезенки 10. Укорочение продолжительности жизни эритроцитов




 Внутрисосудистый гемолиз 1. Бледность кожный покровов преобладает над желтушностью 2. Нормохромная анемия 3. Увеличение ретикулоцитов крови 4. Появление нормобластов в крови 5. Раздражение эритроидного ростка 6. Повышение свободного гемоглобина сыворотки 7. Снижение концентрации гаптоглобина сыворотки 8. Моча цвета «мясных помоев» , гемоглобинурия++++, гемосидеринурия 9. Нет спленомегалии 10. Олигоанурия, увеличение креатинина (ОПН)
Внутрисосудистый гемолиз 1. Бледность кожный покровов преобладает над желтушностью 2. Нормохромная анемия 3. Увеличение ретикулоцитов крови 4. Появление нормобластов в крови 5. Раздражение эритроидного ростка 6. Повышение свободного гемоглобина сыворотки 7. Снижение концентрации гаптоглобина сыворотки 8. Моча цвета «мясных помоев» , гемоглобинурия++++, гемосидеринурия 9. Нет спленомегалии 10. Олигоанурия, увеличение креатинина (ОПН)

 Лабораторные тесты Анемия Увеличение количества ретикулоцитов Морфология эритроцитов Лейкоцитоз Увеличение ЛДГ Увеличение непрямого билирубин Уменьшение гаптоглобина Гемоглобинурия Гемосидеринурия
Лабораторные тесты Анемия Увеличение количества ретикулоцитов Морфология эритроцитов Лейкоцитоз Увеличение ЛДГ Увеличение непрямого билирубин Уменьшение гаптоглобина Гемоглобинурия Гемосидеринурия
 Лабораторные тесты Дополнительные тесты • Реакция Кумбса • Осмотическая стойкость эритроцитов • Электрофорез Hb • Исследование ферментов эритроцитов • Исследование костного мозга изменение М: Э соотношения
Лабораторные тесты Дополнительные тесты • Реакция Кумбса • Осмотическая стойкость эритроцитов • Электрофорез Hb • Исследование ферментов эритроцитов • Исследование костного мозга изменение М: Э соотношения
 Проба Кумбса Антиглобулиновая сывоотка
Проба Кумбса Антиглобулиновая сывоотка
 Реакция Кумбса • Определяет антитела, обволакивающие эритроциты • Позитивный тест не обязательно означает наличие гемолиза – 1/10000 здоровых – 5 -10% госпитализированных • Определяет 100 -500 молекул Ig. G – меньшее количество может приводить к гемолизу – может не определяться Ig. A и Ig. G 4 • Нет корреляции с гемолизом
Реакция Кумбса • Определяет антитела, обволакивающие эритроциты • Позитивный тест не обязательно означает наличие гемолиза – 1/10000 здоровых – 5 -10% госпитализированных • Определяет 100 -500 молекул Ig. G – меньшее количество может приводить к гемолизу – может не определяться Ig. A и Ig. G 4 • Нет корреляции с гемолизом
 Аутоиммунные гемолитические анемии Ø С тепловыми агглютининами Ø С тепловыми гемолизинами Ø С холодовыми гемолизинами Ø Пароксизмальная холодовая гемоглобинурия
Аутоиммунные гемолитические анемии Ø С тепловыми агглютининами Ø С тепловыми гемолизинами Ø С холодовыми гемолизинами Ø Пароксизмальная холодовая гемоглобинурия
Лечение 1. Преднизолон первичный ответ у 2/3 2. Спленэктомия ответ у 2/3 3. Иммунодепрессии 10% рефракторный к стероидам и спленэктомии. иммуран, циклофосфан, циклоспорин, даназол, Ig 4. Мабтера
Лечение 1. Преднизолон первичный ответ у 2/3 2. Спленэктомия ответ у 2/3 3. Иммунодепрессии 10% рефракторный к стероидам и спленэктомии. иммуран, циклофосфан, циклоспорин, даназол, Ig 4. Мабтера
 Лечение АИГА с полными холодовыми антителами 1. Лечение основного заболевания - ЛПЗ - вирус-преходяще 2. Избегать охлаждения - не переливать холодную кровь 3. Стероиды и спленэктомия- малоэффективны 4. Цитостатики - хлорбутин - циклофосфан 5. Мабтера 6. Плазмаферез
Лечение АИГА с полными холодовыми антителами 1. Лечение основного заболевания - ЛПЗ - вирус-преходяще 2. Избегать охлаждения - не переливать холодную кровь 3. Стероиды и спленэктомия- малоэффективны 4. Цитостатики - хлорбутин - циклофосфан 5. Мабтера 6. Плазмаферез
 Пароксизмальная ночная гемоглобинурия Ø Патология стволовой клетки Ø Появление патологического клона эритроцитов (гранулоцитов, тромбоцитов), имеющих мембранные дефекты, что приводит к повышенной чувствительности клеток к комплементу и внутрисосудистому гемолизу
Пароксизмальная ночная гемоглобинурия Ø Патология стволовой клетки Ø Появление патологического клона эритроцитов (гранулоцитов, тромбоцитов), имеющих мембранные дефекты, что приводит к повышенной чувствительности клеток к комплементу и внутрисосудистому гемолизу
 Пароксимальная ночная гемоглбинурия Сон Гиповентиляция Закисление плазмы Активация комплемента Усиление гемолиза
Пароксимальная ночная гемоглбинурия Сон Гиповентиляция Закисление плазмы Активация комплемента Усиление гемолиза
 Диагностические критерии Ø Синдром внутрисосудистого гемолиза Ø Пояление мочи цвета «мясных помоев» после сна Ø Синдром панцитопении при сохраненной клеточности или гиперплазии костного мозга Ø Кислотная проба Хема Ø Сахарозная проба Гартмана Ø Отрицательная проба Кумбса
Диагностические критерии Ø Синдром внутрисосудистого гемолиза Ø Пояление мочи цвета «мясных помоев» после сна Ø Синдром панцитопении при сохраненной клеточности или гиперплазии костного мозга Ø Кислотная проба Хема Ø Сахарозная проба Гартмана Ø Отрицательная проба Кумбса
 Апластическая анемия Ø Состояние, характеризующееся панцитопенией в периферической крови с гипоплазией костного мозга в отутствии его патологической инфильтрации и миелофиброза Ø Морфологическая основа – преобладание жировой ткани над гематогенной
Апластическая анемия Ø Состояние, характеризующееся панцитопенией в периферической крови с гипоплазией костного мозга в отутствии его патологической инфильтрации и миелофиброза Ø Морфологическая основа – преобладание жировой ткани над гематогенной
 Состояние, характеризующееся заметным уменьшением или исчезновением эритроидных, гранулоцитарных и мегакариоцитарных клеток в костном мозге с развитием панцитопении и уменьшением количества СD 34+ и колонииформирующих клеток.
Состояние, характеризующееся заметным уменьшением или исчезновением эритроидных, гранулоцитарных и мегакариоцитарных клеток в костном мозге с развитием панцитопении и уменьшением количества СD 34+ и колонииформирующих клеток.
 Панцитопенический синдром Ø Ø Ø Ø Миелодиспластический синдром Алейкемический вариант острого лейкоза Лимфомы костного мозга Миеломная болезнь ПНГ Миелофиброз Волосато- клеточный лейкоз СКВ Гиперспленизм В 12 и фолиевый дефицит Саркоидоз, туберкулез, лейшманиоз Метастазы рака в костный мозг Токсическое воздействвие (лучевая и химиотерапия)
Панцитопенический синдром Ø Ø Ø Ø Миелодиспластический синдром Алейкемический вариант острого лейкоза Лимфомы костного мозга Миеломная болезнь ПНГ Миелофиброз Волосато- клеточный лейкоз СКВ Гиперспленизм В 12 и фолиевый дефицит Саркоидоз, туберкулез, лейшманиоз Метастазы рака в костный мозг Токсическое воздействвие (лучевая и химиотерапия)
 Клиника апластической анемии Ø Геморрагический диатез Ø Гнойно-некротические инфекционные осложнения Ø Анемия Ø Интоксикация
Клиника апластической анемии Ø Геморрагический диатез Ø Гнойно-некротические инфекционные осложнения Ø Анемия Ø Интоксикация
 Проявления геморрагического диатеза в полости рта
Проявления геморрагического диатеза в полости рта
 Проявления геморрагического диатеза у больной апластической анемией
Проявления геморрагического диатеза у больной апластической анемией
 Кровоизлияния в склеры у больной апластической анемией
Кровоизлияния в склеры у больной апластической анемией
 Течение и прогноз Ø Только при проведении трансфузионной терапии 80% пациентов живут от 18 до 24 мес Ø При проведении ТКМ и иммуносупрессивной терапии – 60 -90% случаев курабельны, риск РТПХ. Ø Эволюция в клональное заболевание в 15% в МДС или ПНГ ( выше при проведении иммуносупрессивной терапиии )
Течение и прогноз Ø Только при проведении трансфузионной терапии 80% пациентов живут от 18 до 24 мес Ø При проведении ТКМ и иммуносупрессивной терапии – 60 -90% случаев курабельны, риск РТПХ. Ø Эволюция в клональное заболевание в 15% в МДС или ПНГ ( выше при проведении иммуносупрессивной терапиии )
 Трансплантация ГСК от гистосовместимого донора Длительная выживаемость – 90% Наличие совместимого донора – у 25 - 30% Показания: тяжелая и средней тяжести апластическая анемия, статус Карновского 80% и более Ø Кондиционирование: циклофосфан 50 мг/кг Д 5 -4 -3 -2 АЛГ 30 мг/кг Д 5 -4 -3 метилпреднизолон 2 мг/кг Д 5 -4 -3 Профилактика РТПХ циклоспорином А 6 -12 мес Ø Ø Ø
Трансплантация ГСК от гистосовместимого донора Длительная выживаемость – 90% Наличие совместимого донора – у 25 - 30% Показания: тяжелая и средней тяжести апластическая анемия, статус Карновского 80% и более Ø Кондиционирование: циклофосфан 50 мг/кг Д 5 -4 -3 -2 АЛГ 30 мг/кг Д 5 -4 -3 метилпреднизолон 2 мг/кг Д 5 -4 -3 Профилактика РТПХ циклоспорином А 6 -12 мес Ø Ø Ø
 Иммуносупрессивная терапия при отсутствии HLA- идентичного донора Ø АЛГ мышиный, козий, кроличий (АТГАМ, АТГ, антилимфолин, тимоглобулин) 1520 мг/кг 5 -7 дней Ø Циклоспорин А 5 мг/кг 1 -112 день под контролем концентрации в плазме Ø Метилпреднизолон 1 мг/кг 1 -14 день с отменой к 28 дню
Иммуносупрессивная терапия при отсутствии HLA- идентичного донора Ø АЛГ мышиный, козий, кроличий (АТГАМ, АТГ, антилимфолин, тимоглобулин) 1520 мг/кг 5 -7 дней Ø Циклоспорин А 5 мг/кг 1 -112 день под контролем концентрации в плазме Ø Метилпреднизолон 1 мг/кг 1 -14 день с отменой к 28 дню
 Гипохромные микроцитарные Ø Железодефицитные анемии Ø Анемии хронических заболеваний Ø Сидероахрестические анемии (нарушение синтеза гема) Ø Талассемии (нарушение синтеза глобина)
Гипохромные микроцитарные Ø Железодефицитные анемии Ø Анемии хронических заболеваний Ø Сидероахрестические анемии (нарушение синтеза гема) Ø Талассемии (нарушение синтеза глобина)
 Нормохромные нормоцитарные Заболевания, которые сопровождаются уменьшением уровня эритропоэтина (болезни почек) Ø Ранние стадии развития анемии хронических заболеваний Ø Заболевания, которые могут привести к неспособности костного мозга ответить на эритропоэтин (лейкозы, метастазы в костный мозг) Ø Недавняя кровопотеря Ø
Нормохромные нормоцитарные Заболевания, которые сопровождаются уменьшением уровня эритропоэтина (болезни почек) Ø Ранние стадии развития анемии хронических заболеваний Ø Заболевания, которые могут привести к неспособности костного мозга ответить на эритропоэтин (лейкозы, метастазы в костный мозг) Ø Недавняя кровопотеря Ø
 Нормохромные нормоцитарные Эндокринные дефициты (гипопитуитаризм, гипокортицизм, гипотиреоз, гипогонадизм) Ø Первичная рефрактерная анемия(МДС) Ø Частичная красноклеточная аплазия Ø Гемолиз Ø Апластическая анемия Ø Смешанный дефицит железа, вит. В 12 и/или фолиевой кислоты Ø Истощение (дефицит белка) Ø
Нормохромные нормоцитарные Эндокринные дефициты (гипопитуитаризм, гипокортицизм, гипотиреоз, гипогонадизм) Ø Первичная рефрактерная анемия(МДС) Ø Частичная красноклеточная аплазия Ø Гемолиз Ø Апластическая анемия Ø Смешанный дефицит железа, вит. В 12 и/или фолиевой кислоты Ø Истощение (дефицит белка) Ø
 Макроцитарные анемии Ø Гиперхромные Ø Нормохромные -дефицит витамина В 12 -дефицит фолиевой кислоты -апластическая анемия -гемолиз -МДС -гипотиреоз -заболевания печени
Макроцитарные анемии Ø Гиперхромные Ø Нормохромные -дефицит витамина В 12 -дефицит фолиевой кислоты -апластическая анемия -гемолиз -МДС -гипотиреоз -заболевания печени
 Алгоритм диагностики нормоцитарных нормохромных анемий Количество ретикулоцитов в крови повышено нормальное или сниженное Анамнез, клинические и инструментальные данные, уровень билирубина постгемолитич. геморраг. анемия нормальные данные ферритин норма повышен стернальная пункция, анемия хр. трепанбиопсия заболевания апластич. анемия МДС заболевания печени почек эндокр. с-мы скрытая В 12 деф. анемия инфильтрация к. м. опухол. кл.
Алгоритм диагностики нормоцитарных нормохромных анемий Количество ретикулоцитов в крови повышено нормальное или сниженное Анамнез, клинические и инструментальные данные, уровень билирубина постгемолитич. геморраг. анемия нормальные данные ферритин норма повышен стернальная пункция, анемия хр. трепанбиопсия заболевания апластич. анемия МДС заболевания печени почек эндокр. с-мы скрытая В 12 деф. анемия инфильтрация к. м. опухол. кл.
 Макроцитарные анемии Ретикулоциты повышены норма понижены - Гемолиз - болезни печени - аплазия - Ответ на вит. В 12 - гипотиреоз - дефицит - МДС витамина В 12 - лекарственные - дефицит воздействия фолиевой кислоты - МДС
Макроцитарные анемии Ретикулоциты повышены норма понижены - Гемолиз - болезни печени - аплазия - Ответ на вит. В 12 - гипотиреоз - дефицит - МДС витамина В 12 - лекарственные - дефицит воздействия фолиевой кислоты - МДС
 Алгоритм диагностики макроцитарных анемий Морфология крови и костного мозга Мегалобластический эритропоэз Немегалобластический эритропоэз Определение уровня витамина В 12 и фолиевой кислоты в сыворотке крови витамина В 12 фолиевой к-ты вит. В 12 фол. к-ты В 12 -деф. Фолиеводеф. Нарушение анемия всасывания (энтерит амилоидоз СПРУ и т. д. ) Количество ретикулоцитов повышено норма в норме -кровотечение -алкоголизм -гемолиз -б-ни печени -гипотиреоз Насл. Лек. -МДС заб-я обусл. -апластич. анемия
Алгоритм диагностики макроцитарных анемий Морфология крови и костного мозга Мегалобластический эритропоэз Немегалобластический эритропоэз Определение уровня витамина В 12 и фолиевой кислоты в сыворотке крови витамина В 12 фолиевой к-ты вит. В 12 фол. к-ты В 12 -деф. Фолиеводеф. Нарушение анемия всасывания (энтерит амилоидоз СПРУ и т. д. ) Количество ретикулоцитов повышено норма в норме -кровотечение -алкоголизм -гемолиз -б-ни печени -гипотиреоз Насл. Лек. -МДС заб-я обусл. -апластич. анемия
 Алгоритм диагностики микроцитарных гипохромных анемий Гипохромная и/или микроцитарная анемия Уровень сывороточного железа Снижен В норме Повышен Ферритин Электрофорез Hb сидеробластов в к. м. Снижен Железо-деф. анемия в норме или Анемия хронических заболеваний Талассемия, гемоглобинопатии Сидероахрестическая анемия
Алгоритм диагностики микроцитарных гипохромных анемий Гипохромная и/или микроцитарная анемия Уровень сывороточного железа Снижен В норме Повышен Ферритин Электрофорез Hb сидеробластов в к. м. Снижен Железо-деф. анемия в норме или Анемия хронических заболеваний Талассемия, гемоглобинопатии Сидероахрестическая анемия


